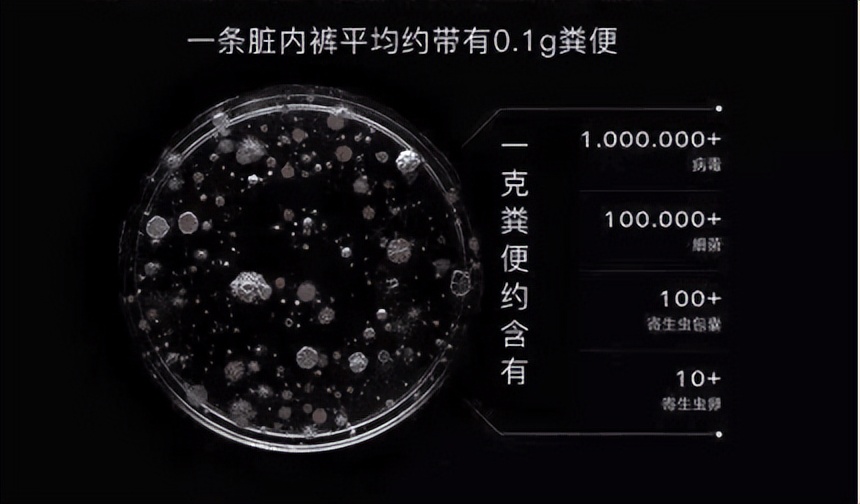
99.9%内衣内裤专用洗衣液测评,竹马之友内衣

每天跟我们24小时亲密接触的 *裤内**
竟然是 健康的凶手 !
如果你还把*裤内**和衣物混洗
你不觉得可怕吗?

高倍显微镜下
*裤内**清洗不干净霉菌滋生过程
之前有项报道称:
“1克粪便含有1000万种病毒、100万种细菌、1000个寄生虫包囊和100个虫卵。
而0.1g粪便就约等于
数以百万计微生物沾染在*裤内**上
要知道, 没洗干净的*裤内** 很容易有 细菌滋生 ,久而久之就会导致*处私**有异味、瘙痒、白带异常……

竹马之友内衣裤洗衣液抑菌

所以,你有好好的清洁你的*裤内**吗?
大部分人都是用洗衣液、洗衣粉或是肥皂来洗*裤内**的…

但是,普通的 碱性清洗剂 不仅不能杀死*裤内**上面的细菌,
还会 破坏*处私**弱酸性 的环境!

这时候,就需要一款能 有效清洁、抑菌 的内衣裤专用洗衣液了!


竹马之友内衣裤洗衣液
去离子水+温和表面活性剂的复合配方,
清洁力更强,能深入到纤维内部把污渍给揪出来!

它不但专门针对女性健康 抑菌 研制,
还 强力去渍、温和不伤衣不伤手
贴身内衣裤、亲肤床品、婴儿衣物...
都可以放心交给它!
就像聘请了一位 私密处的贴身管家 ,
无微不至地呵护你!

01 / 99.9%抑菌率/

竹马之友内衣裤洗衣液抑菌成分
竹马之友内衣裤洗衣液不仅仅能瓦解污渍,
还可以: 抑菌、除螨、消臭!
它专门针对三大“*处私**嗜肉菌”
(大肠杆菌、金黄色葡萄球菌、白色念珠菌)
灭菌率高达99.9%以上
(第三方专业权威机构检测)
从根本上预防妇科疾病的发生
不给细菌任何可趁之机!
轻松帮你 除去螨虫、细菌~
洗的干净,穿的放心!

竹马之友内衣裤洗衣液效果

02 / 三重去渍技术 /

竹马之友内衣裤洗衣液3重去渍技术
主要成分:
表面活性因子+纳米银离子+酵母蛋白酶
温和无刺激,没有科技与狠活 可以轻松瓦解顽固污渍
女生最头疼的 血渍、黄渍、分泌物
都可以温和干净去除
只需在有污渍的地方挤上一点点,
就能慢慢溶解淡化, 一搓就干干净净!

给我们*处私**肌肤更为安全的环境~

03 / 温和洗涤,持久留香 /

竹马之友内衣裤洗衣液金银花香味
金银花天然提取香氛
去除尴尬异味,自然清新
留香持久,呵护*处私**健康
易漂洗无残留
0荧光剂、 0增白剂、 0磷
母婴衣物也可放心使用

竹马之友内衣裤洗衣液易漂洗

竹马之友内衣裤洗衣液使用技巧
除了贴身的内衣裤,孕妇贴身衣物,婴幼儿的贴身衣物、日常的枕头套与床单也可以放心交给它
小小一瓶,轻松帮你 除去污渍、螨虫、细菌~

竹马之友内衣裤洗衣液海报

竹马之友内衣裤洗衣液信息
洗衣新矩阵,洗净护合一
守护全家人的*处私**健康
从一瓶 竹马之友内衣裤专用洗衣液 开始吧
专注内衣裤清洁领域
除菌更高效,不伤衣物不伤肤
爱自己爱家人,家庭洁净健康必备!

竹马之友内衣裤洗衣液